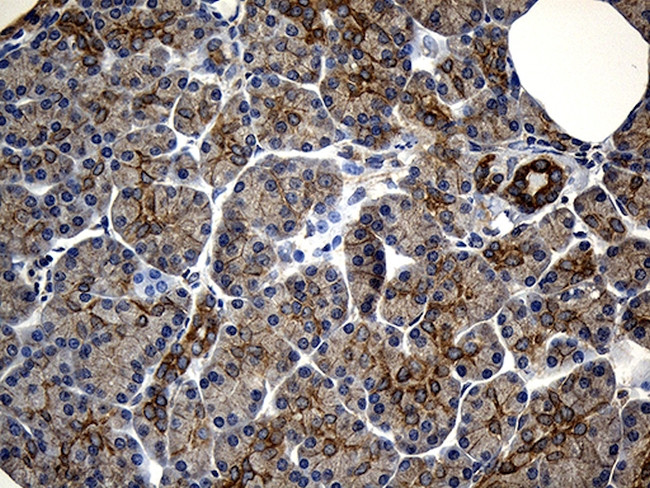
NFKBIE Antibody in Immunohistochemistry (Paraffin) (IHC (P))

Search
OriGene
NFKBIE Monoclonal Antibody (OTI6H8), TrueMAB™
{{$productOrderCtrl.translations['antibody.pdp.commerceCard.promotion.promotions']}}
{{$productOrderCtrl.translations['antibody.pdp.commerceCard.promotion.viewpromo']}}
{{$productOrderCtrl.translations['antibody.pdp.commerceCard.promotion.promocode']}}: {{promo.promoCode}} {{promo.promoTitle}} {{promo.promoDescription}}. {{$productOrderCtrl.translations['antibody.pdp.commerceCard.promotion.learnmore']}}
产品信息
CF810713
种属反应
宿主/亚型
分类
类型
克隆号
抗原
偶联物
形式
浓度
规格
纯化类型
保存液
内含物
保存条件
运输条件
产品详细信息
For reconstitution, we recommend adding 100 µL distilled water to a final antibody concentration of about 1 mg/mL. To use this carrier-free antibody for conjugation experiments, we strongly recommend performing another round of desalting. (Zeba Spin Desalting Columns, 7KMWCO, 0.5 mL, Product # 89882)
靶标信息
NFKB1 or NFKB2 is bound to REL, RELA, or RELB to form the NFKB complex. The NFKB complex is inhibited by I-kappa-B proteins (NFKBIA, MIM 164008 or NFKBIB, MIM 604495), which inactivate NF-kappa-B by trapping it in the cytoplasm. Phosphorylation of serine residues on the I-kappa-B proteins by kinases (IKBKA, MIM 600664, or IKBKB, MIM 603258) marks them for destruction via the ubiquitination pathway, thereby allowing activation of the NF-kappa-B complex. Activated NFKB complex translocates into the nucleus and binds DNA at kappa-B-binding motifs such as 5-prime GGGRNNYYCC 3-prime or 5-prime HGGARNYYCC 3-prime (where H is A, C, or T; R is an A or G purine; and Y is a C or T pyrimidine). For some genes, activation requires NFKB interaction with other transcription factors, such as STAT (see STAT6, MIM 601512), AP1 (JUN, MIM 165160), and NFAT (see NFATC1, MIM 600489).
仅用于科研。不用于诊断过程。未经明确授权不得转售。
篇参考文献 (0)
生物信息学
蛋白别名: I-kappa-B-epsilon; ikappaBepsilon; IkB epsilon; IkB-E; ikB-epsilon; IkBepsilon; NF-kappa-B inhibitor epsilon; NF-kappa-BIE; nuclear factor of kappa light polypeptide gene enhancer in B-cells inhibitor, epsilon; unnamed protein product
基因别名: IKBE; NFKBIE
UniProt ID: (Human) O00221
Entrez Gene ID: (Human) 4794